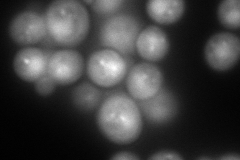
YPR173C
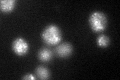
YPR173C

View description
AAA-ATPase involved in multivesicular body (MVB) protein sorting, ATP-bound Vps4p localizes to endosomes and catalyzes ESCRT-III disassembly and membrane release; ATPase activity is activated by Vta1p; regulates cellular sterol metabolism
Localization:
Intensity:
Fold change:
Significance:
-
C’ GFP library in SD

punctate35.81 -
N' NOP1pr-GFP in SD

punctate198.071 -
N' TEF2pr-mCherry in SD
punctate,nucleus250.652 -
N' NATIVEpr-GFP in SD

punctate24.0294 -
N' TEF2pr-VC and Cyto-VN in SD

cytosol,punctate60.6995 -
C’ GFP library in SD+DTT
punctate36.041No -
C’ GFP library in SD+H2O2

punctate31.840.88No -
C’ GFP library in Starvation Media

punctate41.861.16No -
C’ GFP library on the background of Pup2-DaMP

punctate -
C’ GFP library on the background of CCT mutant

punctate35.42860.989151No
